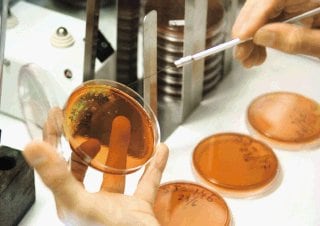

Nueve pacientes se mantienen aislados en el hospital Calderón Guardia afectados por un nuevo brote de la bacteria Clostridium difficile , la misma que hace más de un año habría causado la muerte de 17 pacientes en el San Juan de Dios.
Dicho microorganismo se desarrolla cuando una persona toma antibióticos durante un tiempo prolongado, o bien cuando un paciente enfermo lo transmite.
La bacteria provoca fiebre, vómitos, diarrea severa y daña el colon y, en algunos casos, puede causar la muerte.
Las nueve personas a quienes se les detectó la bacteria se mantienen estables, informó ayer Daniel Rodríguez, jefe de medicina de dicho centro médico.
El descubrimiento del aumento de los casos ocurrió la semana pasada, cuando, tras varios análisis clínicos, los médicos del Calderón Guardia y expertos de la Universidad de Costa Rica confirmaron la presencia de la bacteria en varias muestras tomadas a los pacientes.
Debido a ello, las autoridades del hospital capitalino aislaron a los pacientes en un solo salón.
Según Rodríguez, entre los afectados hay desde jóvenes hasta ancianos de 80 años.
Menos agresiva. Roy Wong, epidemiólogo de la Caja Costarricense de Seguro Social (CCSS) informó de que la cepa de la Clostridium difficile detectada en el Calderón Guardia no es la misma que en su momento de halló en el hospital San Juan de Dios.
“La bacteria no pertenece a la cepa hipervirulenta”, dijo.
Hasta el viernes anterior, las autoridades del Calderón no habían declarado ninguna muerte a causa de la bacteria.
Ayer se intentó obtener el criterio de Luis Paulino Hernández, director del Calderón Guardia, pero al cierre de edición no había devuelto los mensajes dejados a su secretaria y en su teléfono celular.
Por otra parte, Enrique San Gil, epidemiólogo del San Juan de Dios, dijo ayer que en ese centro médico tienen controlada la presencia de la bacteria Clostridium difficile .
Afirmó que ese hospital presenta unos ocho casos al mes, “lo cual está dentro de lo normal”.
Entorno aseado. San Gil explicó que la buena higiene es fundamental para evitar adquirir la bacteria.
“Muchos de los contagios se presentan por contacto con superficies contaminadas, como servicios sanitarios y agarraderos”, dijo.
También, según San Gil, hay contagios por vía “anomanoboca”, es decir, material fecal que se digiere de alguna manera (un saludo de manos, alimentos, etc).